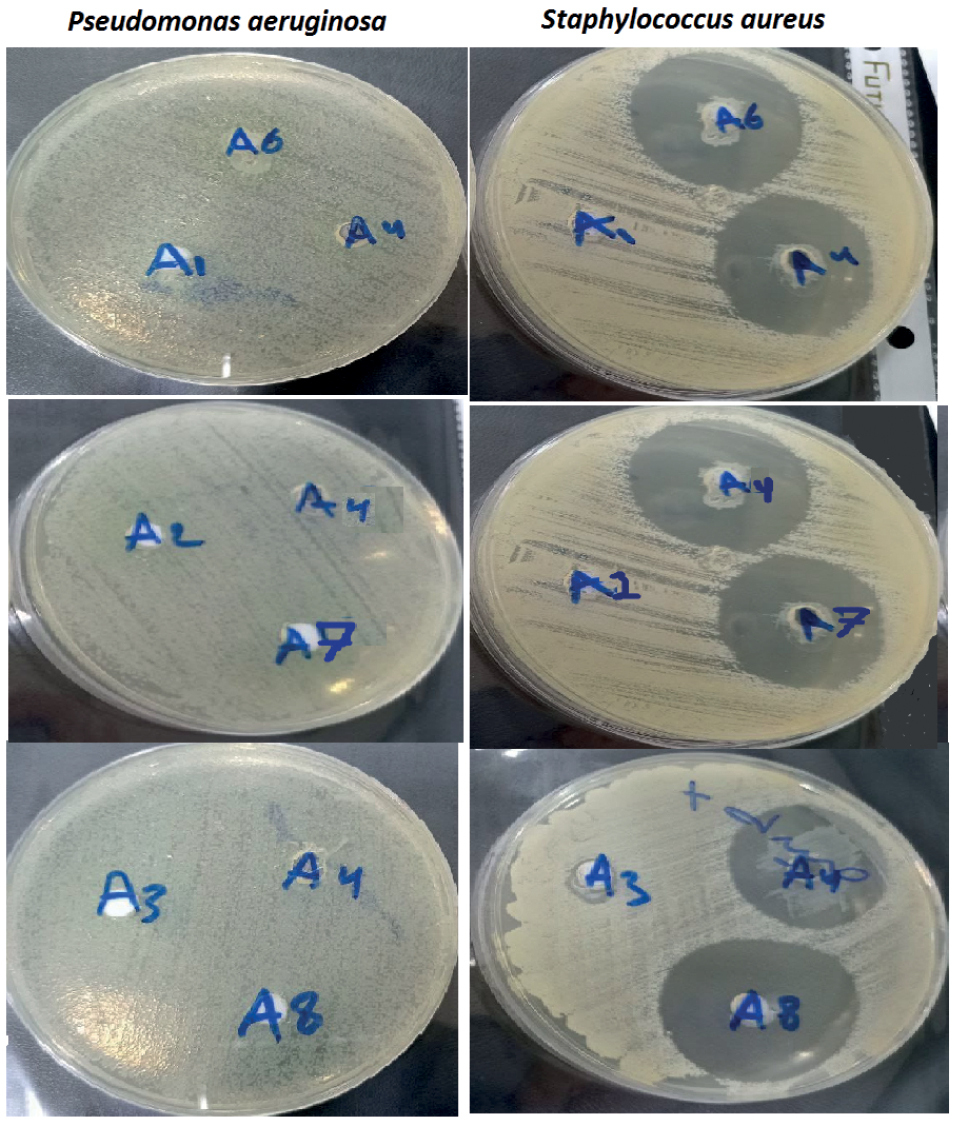
Clindamycin And Metronidazole industry insight

The global market for topical and oral antibiotics, including combination therapies like clindamycin and metronidazole, has experienced steady growth driven by rising incidences of bacterial infections, acne vulgaris, and gastrointestinal disorders. According to Grand View Research, the global antibiotics market was valued at USD 52.02 billion in 2023 and is expected to expand at a compound annual growth rate (CAGR) of 5.8% from 2024 to 2030. A significant portion of this growth is attributed to increased demand for effective antimicrobial formulations, particularly in dermatology and gastroenterology. Clindamycin, known for its potency against Gram-positive and anaerobic bacteria, and metronidazole, widely used for its antiprotozoal and antibacterial properties, are frequently co-prescribed or formulated in combination products. With rising antibiotic resistance and the need for targeted therapies, manufacturers capable of producing high-purity, cost-effective, and scalable versions of these agents are gaining competitive advantage. This data-backed demand has amplified the prominence of key pharmaceutical manufacturers specializing in clindamycin and metronidazole, both as standalone and combination drugs.
Top 7 Clindamycin And Metronidazole Manufacturers 2026
(Ranked by Factory Capability & Trust Score)
#1 ANTIBIOTICS, VAGINAL
Domain Est. 2007
Website: txvendordrug.com
Key Highlights: ANTIBIOTICS, VAGINAL ; Brand Name/Generic Name CLINDAMYCIN 2% VAGINAL CREAM – 40GM clindamycin phosphate ; NDC/Manufacturer 00168027740. FOUGERA/SANDOZ ; FFS ……
#2 acnil clindamycin hydrochloride and metronidazole liniment liniment
Domain Est. 1997
Website: dailymed.nlm.nih.gov
Key Highlights: It is a compound preparation. Each milliliter contains 10.0 mg of Clindamycin Hydrochloride (calculated as Clindamycin)….
#3 Efficacy of Oral Metronidazole with Vaginal Clindamycin or …
Domain Est. 1997
Website: pmc.ncbi.nlm.nih.gov
Key Highlights: Vaginal 2% clindamycin cream was in a plain white tube and prescribed as one applicator vaginally for 7 nights. The probiotic and placebo were ……
#4 Metronidazole
Domain Est. 1999
Website: medcentral.com
Key Highlights: Metronidazole is used orally in the treatment of acute intestinal amebiasis and amebic liver abscess caused by Entamoeba histolytica….
#5 SagentPharma®
Domain Est. 2006
Website: sagentpharma.com
Key Highlights: Sagent is a leading provider of generic pharmaceuticals. Our product portfolio spans multiple therapeutic categories and a variety of packaging ……
#6 [PDF] Clinical Practice Guidelines for Antimicrobial Prophylaxis in Surgery
Domain Est. 1996
Website: ashp.org
Key Highlights: cillin include either clindamycin or metronidazole plus an aminoglycoside or a fluoroquinolone (ciprofloxacin, levo- floxacin, or moxifloxacin) or aztreonam ……
#7 Clindamycin
Domain Est. 2011
Website: hopkinsguides.com
Key Highlights: Clindamycin or clindamycin + PNC are advocated for devastating streptococcal soft tissue infections, including necrotizing fasciitis, myositis and TSS (NEJM 334 ……
Expert Sourcing Insights for Clindamycin And Metronidazole
H2: Market Trends for Clindamycin and Metronidazole in 2026
As we approach 2026, the global market for Clindamycin and Metronidazole—two widely used antibiotics with distinct antimicrobial profiles—reflects evolving dynamics shaped by public health priorities, antimicrobial resistance (AMR), regulatory developments, and shifting prescribing patterns. These antibiotics remain critical in treating anaerobic bacterial infections, protozoal diseases, and certain skin and gastrointestinal conditions, but their market trajectories are being influenced by several key trends.
-
Growing Focus on Antimicrobial Stewardship
By 2026, antimicrobial stewardship programs have become more entrenched in healthcare systems globally. Regulatory bodies and health organizations are emphasizing the judicious use of antibiotics to combat rising resistance. Clindamycin, associated with Clostridioides difficile (C. diff) infections when overused, faces increased scrutiny. This has led to more restrictive prescribing guidelines, particularly in outpatient settings, potentially slowing market growth. In contrast, Metronidazole—often considered a first-line agent for C. diff and certain parasitic infections—maintains steady demand due to its efficacy and cost-effectiveness, though its long-term use is also being monitored for neurotoxicity and resistance trends. -
Increased Demand in Emerging Markets
In low- and middle-income countries (LMICs), access to affordable antibiotics remains a priority. Both Clindamycin and Metronidazole are available as low-cost generics, supporting their widespread use in treating bacterial vaginosis, intra-abdominal infections, and parasitic diseases like giardiasis and trichomoniasis. By 2026, expanding healthcare infrastructure and rising awareness in regions such as Southeast Asia, Africa, and Latin America are driving volume-based market growth, despite cost pressures on pricing. -
R&D and Formulation Innovations
Pharmaceutical companies are investing in novel delivery systems to improve patient compliance and reduce side effects. For example, topical and vaginal formulations of Clindamycin for acne and bacterial vaginosis continue to see innovation, including gel, foam, and insert technologies. Metronidazole is witnessing interest in extended-release oral forms and combination therapies, particularly with other agents for gastrointestinal infections. These innovations are helping sustain market relevance despite generic competition. -
Regulatory and Safety Concerns
By 2026, regulatory agencies such as the FDA and EMA have issued updated guidance on the use of Clindamycin due to concerns over resistance and C. diff outbreaks. Some formulations are under review for pediatric use, influencing market access. Metronidazole, while still widely used, remains on watchlists due to its potential carcinogenicity in high-dose, long-term animal studies—though human risk remains debated. These factors contribute to cautious prescribing and may limit new market expansions. -
Impact of Digital Health and Telemedicine
The rise of telemedicine platforms has influenced antibiotic prescribing patterns. In 2026, digital diagnostics and AI-driven clinical decision support tools help clinicians choose appropriate antibiotics, often favoring narrower-spectrum agents. This trend is leading to optimized use of Metronidazole in confirmed anaerobic or protozoal cases, while reducing inappropriate Clindamycin prescriptions for viral or non-indicated conditions. -
Market Competition and Pricing Pressures
Both drugs are off-patent and available from multiple generic manufacturers, leading to intense price competition. In 2026, this results in flat or declining revenue growth in mature markets like North America and Europe, despite stable or increasing unit sales. Contract manufacturing and supply chain consolidation among generics producers are common strategies to maintain profitability.
Conclusion
The 2026 market for Clindamycin and Metronidazole is characterized by maturity, regulatory oversight, and regional divergence. While global demand remains robust—especially in developing economies—growth is constrained by stewardship efforts, safety monitoring, and pricing dynamics. Metronidazole appears better positioned due to its broader indications and lower resistance profile, whereas Clindamycin faces challenges related to safety and shifting treatment guidelines. Companies active in this space are adapting through formulation innovation, emerging market expansion, and participation in AMR mitigation initiatives.

Common Pitfalls Sourcing Clindamycin and Metronidazole (Quality, IP)
Sourcing active pharmaceutical ingredients (APIs) like Clindamycin and Metronidazole requires careful due diligence to ensure product quality, regulatory compliance, and intellectual property (IP) integrity. Overlooking critical factors can lead to significant risks, including compromised patient safety, regulatory actions, supply chain disruptions, and legal liabilities. Below are key pitfalls to avoid:
Quality-Related Pitfalls
1. Inadequate Supplier Qualification and Audit Failures
Relying solely on documentation without conducting thorough on-site audits of manufacturing facilities can lead to sourcing from non-compliant suppliers. Facilities in certain regions may lack robust quality management systems (QMS), resulting in inconsistent purity, contamination risks, or failure to meet pharmacopeial standards (e.g., USP, Ph. Eur., BP). Skipping audits increases the risk of receiving substandard or counterfeit material.
2. Inconsistent or Inadequate Analytical Testing
Accepting COAs (Certificates of Analysis) without independent verification may expose buyers to falsified data. Clindamycin and Metronidazole are susceptible to degradation under improper storage or manufacturing conditions. Failing to test for impurities (e.g., residual solvents, genotoxic impurities), assay strength, and polymorphic forms can compromise drug safety and efficacy.
3. Poor Supply Chain Transparency and Traceability
Lack of visibility into the supply chain—such as undisclosed subcontractors or multiple sourcing tiers—increases the risk of adulteration or diversion. Both APIs are prone to supply fluctuations; opaque sourcing makes it difficult to trace contamination issues or respond to recalls effectively.
4. Non-Compliance with Regulatory Standards
Sourcing from manufacturers without active regulatory filings (e.g., DMFs in the US, ASMFs in Europe) or those operating in jurisdictions with weak regulatory oversight can result in rejected shipments or regulatory delays. Clindamycin, in particular, has stringent specifications due to its narrow therapeutic index and potential for C. difficile overgrowth if underdosed.
Intellectual Property (IP) Pitfalls
1. Infringement of Patents and Regulatory Exclusivity
Using or sourcing APIs covered by active compound, formulation, or process patents without proper licensing exposes companies to litigation and market withdrawal. While Clindamycin and Metronidazole are largely off-patent, certain novel formulations, delivery systems, or salt forms may still be protected. Failing to conduct freedom-to-operate (FTO) analyses can lead to costly IP disputes.
2. Reliance on Unverified “Generic” Suppliers with Questionable IP Practices
Some suppliers may claim to offer “generic” APIs but use patented manufacturing processes or infringe on process patents. This is particularly risky with Metronidazole, where specific synthesis routes may be protected. Sourcing from such suppliers implicates the buyer in indirect infringement.
3. Counterfeit or Diverted Materials with Fake Documentation
Illicit suppliers may provide falsified documentation suggesting IP compliance and quality, while supplying counterfeit or diverted APIs. These materials may originate from overproduction, expired stock, or unauthorized facilities, posing both quality and IP risks, especially if trademarked or patented formulations are involved.
Mitigation Strategies
To avoid these pitfalls, buyers should:
– Conduct rigorous supplier audits (including third-party assessments).
– Require complete and current regulatory documentation (DMF, CEP, GMP certificates).
– Perform independent batch testing using accredited laboratories.
– Implement robust supply chain mapping and track-and-trace systems.
– Engage legal counsel to perform FTO analyses before sourcing.
– Prefer suppliers with transparent operations and a history of regulatory compliance.
Proactive management of both quality and IP aspects is essential to ensure safe, compliant, and sustainable sourcing of Clindamycin and Metronidazole APIs.

Logistics & Compliance Guide for Clindamycin and Metronidazole
Storage Requirements
Clindamycin and Metronidazole must be stored under specific conditions to maintain their efficacy and ensure patient safety.
-
Clindamycin: Store at controlled room temperature between 20°C to 25°C (68°F to 77°F), with excursions permitted between 15°C to 30°C (59°F to 86°F). Protect from moisture and light. Injectable forms should be inspected for particulate matter or discoloration before use.
-
Metronidazole: Oral tablets and capsules should be stored at 20°C to 25°C (68°F to 77°F), with similar allowable excursions. The injectable solution should also be protected from light and freezing. Avoid prolonged exposure to temperatures above 40°C.
Both medications should be kept in their original packaging until dispensed.
Transportation Guidelines
Transportation of Clindamycin and Metronidazole must comply with pharmaceutical cold chain standards where applicable.
- Maintain temperature control during transit using validated shipping containers or refrigerated transport if required.
- Use temperature-monitoring devices (e.g., data loggers) for all shipments, especially for liquid or injectable formulations.
- Ensure timely delivery to prevent extended exposure to adverse conditions.
- Shipments should be labeled appropriately with “Pharmaceutical – Store as Directed” and include handling instructions.
Regulatory Compliance
Distribution and handling of Clindamycin and Metronidazole are subject to national and international regulatory standards.
- FDA (U.S.): Both drugs are approved prescription medications. Compliance with Current Good Manufacturing Practices (CGMP) and 21 CFR Part 211 is mandatory for manufacturers and distributors.
- EU (EMA): Follow EU GMP guidelines. Classification under Annex I of the EU Falsified Medicines Directive (FMD) may require safety features such as unique identifiers and anti-tampering devices.
- DEA Classification: Neither Clindamycin nor Metronidazole is a controlled substance under the U.S. Controlled Substances Act, but they require valid prescription authorization for dispensing.
All entities in the supply chain must maintain proper licensing and comply with local pharmaceutical distribution laws.
Import/Export Documentation
International movement of Clindamycin and Metronidazole requires thorough documentation.
- Certificate of Analysis (CoA): Must accompany each batch, verifying identity, potency, and purity.
- Good Manufacturing Practice (GMP) Certificate: Required by many countries to confirm manufacturing compliance.
- Import License: Required in most countries for pharmaceutical imports.
- Customs Declaration: Accurate HS codes (e.g., 3004.32 for antibiotics) must be used.
- Prior Notification: Some jurisdictions require advance notification for antibiotic imports due to antimicrobial resistance concerns.
Ensure all documentation is translated if required and submitted in advance to prevent customs delays.
Stability and Shelf Life
Understanding the stability of Clindamycin and Metronidazole is essential for inventory management.
- Clindamycin:
- Oral capsules: Typically 24–36 months from manufacture.
-
Injectable: 18–24 months; reconstituted solution stable for 24 hours at room temperature or 7 days under refrigeration.
-
Metronidazole:
- Tablets: Usually 36 months.
- IV solution: 24–36 months unopened; stable for 24 hours after dilution at room temperature.
Monitor expiration dates rigorously and implement a first-expiry, first-out (FEFO) inventory system.
Handling and Personnel Training
Personnel involved in logistics must be trained in proper pharmaceutical handling.
- Staff should be trained in Good Distribution Practices (GDP) per WHO or national standards.
- Use personal protective equipment (PPE) when handling bulk powders or damaged containers.
- Training should include spill management, cross-contamination prevention, and emergency procedures.
Maintain training records for audit readiness.
Anti-Counterfeiting and Traceability
Both drugs are susceptible to counterfeiting due to widespread use.
- Utilize serialization and barcoding aligned with regulatory track-and-trace systems (e.g., U.S. DSCSA, EU FMD).
- Verify authenticity via supplier audits and batch testing when necessary.
- Report suspicious products to regulatory authorities (e.g., FDA MedWatch, EMA EudraVigilance).
Environmental and Disposal Compliance
Expired or damaged products must be disposed of responsibly.
- Follow local hazardous waste regulations; although not classified as highly hazardous, antibiotics should not enter water systems.
- Use certified pharmaceutical waste disposal services.
- Maintain disposal records for compliance audits.
Proper handling prevents environmental contamination and supports antimicrobial stewardship.
Audit and Recordkeeping
Maintain comprehensive records to support compliance.
- Retain shipping logs, temperature reports, CoAs, and training records for a minimum of 5 years (or per local regulation).
- Conduct internal audits annually to assess adherence to GDP and regulatory requirements.
- Prepare for unannounced inspections by regulatory agencies with up-to-date documentation.
Robust recordkeeping ensures traceability and facilitates rapid response during recalls.
In conclusion, sourcing clindamycin and metronidazole requires careful consideration of regulatory compliance, quality assurance, and supply chain reliability. Both antibiotics are essential for treating a range of bacterial and parasitic infections, with metronidazole being widely accessible and commonly produced globally, while clindamycin may have more restricted availability due to tighter manufacturing controls and regulatory scrutiny. It is crucial to source these medications from reputable, WHO-prequalified, or FDA/EMA-approved manufacturers to ensure product safety, efficacy, and adherence to international standards. Additionally, factors such as cost, lead times, import regulations, and stability of supply must be evaluated to maintain continuity of access, especially in healthcare and pharmaceutical distribution settings. Responsible and ethical sourcing practices not only support patient safety but also help combat antimicrobial resistance by ensuring the integrity and appropriate use of these critical agents.





![[PDF] Clinical Practice Guidelines for Antimicrobial Prophylaxis in Surgery](https://www.sohoinchina.com/wp-content/uploads/2026/01/pdf-clinical-practice-guidelines-for-antimicrobial-prophylaxis-in-surg-143.png)
